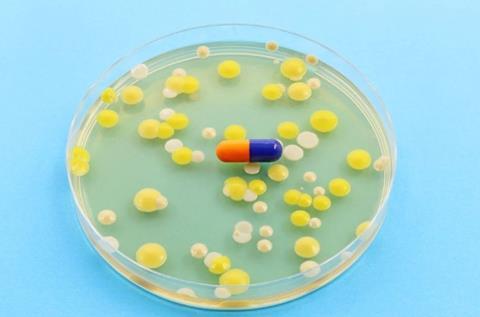
Image

Despite the UK having “a very healthy” therapeutic pipeline, more needs to be done in the fight against antimicrobial resistance (AMR), NovaBiotics’ CEO asserts.
In recent months, Pharma and biotech have seen promising developments in line with their efforts to help overcome global antimicrobial resistance (AMR).
The discovery and use of antibiotics brought about a groundbreaking transformation in the treatment of bacterial infections, substantially reducing the number of deaths associated with microorganism-related diseases in humans and animals. However, the emergence and spread of AMR impacts the effectiveness of these drugs and threatens many achievements of modern medicine, justifying the urgent need to prevent its spread1 as a significant threat to public health.2
According to the 2019 report on global bacterial AMR, 4.95 million people who died in 2019 suffered from drug-resistant bacterial infections.2
In working towards solutions, in November 2023, Sandoz and Teva became the first organisations to qualify for a new global Minimized Risk of Antimicrobial Resistance (AMR) certification. This confirms that the companies are helping to minimise the spread of AMR by taking the essential and valuable actions to ensure responsible antibiotic manufacturing in the global supply chain.
In January, EPR reported on research from GlobalData, which highlighted the potential of the novel antibiotic zosurabalpin to treat a World Health Organisation (WHO)-categorised ‘priority 1 pathogen’.
Positively, alongside zosurabalpin, there are nine other drugs in clinical development for the treatment of acinetobacter infections, GlobalData confirmed. According to Anaelle Tannen, Infectious Disease Analyst at GlobalData, carbapenem-resistant acinetobacter baumanni (CRAB) infections are “very difficult” to treat, a reality that is compounded by the resulting “mortality in up to 60 percent of cases”. Therefore, there is a “high level of unmet need in this indication”.
Tackling AMR in the UK
In a virtual policy conference held by the Westminster Health Forum in January 2024, titled ‘Priorities and next steps for tackling antimicrobial resistance in the UK’, Chief Executive Officer for NovaBiotics, Deborah O'Neil, explored ‘Driving the development of new antibiotics in the UK and the role of biotechnology in tackling AMR'. Primarily, she discussed small medium enterprise (SME) biotechs developing AMR therapeutics.
Current challenges
In her presentation, she shared that within the AMR therapeutics space, especially for SME biotechs, there are “funding issues… the broken commercial market for antimicrobials, [as well as] challenges of investment in this space versus other therapeutic areas.”
Due to these obstacles, “some [UK] companies have moved into other therapeutic areas, [and] those tend to be the later stage companies whose Phase III assets or potentially even commercialised products have failed.”
Developing an innovative and successful sector
Therefore, she emphasised new therapies “are desperately needed in the fight against AMR”, and that promisingly, there is “a very healthy pipeline, as well as companies active in this space”, highlighting NovaBiotics as one of the “UK SME biotechs developing novel solutions”.
As an example, O'Neil noted that while this is the case “probably more so on the diagnostic side [compared to therapeutics]… SME biotechs hold 80 percent of the product candidates for AMR (according to a World Health Organization (WHO) report in 2020)”.
SMEs and biotechs in [the AMR therapeutics] space really are the innovation engine… [particularly for] novel classes"
Summarising this point, she declared that “SMEs and biotechs in [the AMR therapeutics] space really are the innovation engine… [particularly for] novel classes.”
For these companies developing new solutions, she upheld that it is “important to succeed, but also fail fast.”
To support developing of these treatments, she asserted “capacity building access to resource skills, etc, across the UK, is going to be critical, not just for protecting and sustaining the SMEs that we already have in developing solutions for AMRs, but the pipeline coming forward as well”.
capacity building access to resource skills, etc, across the UK, is going to be critical, not just for protecting and sustaining the SMEs that we already have in developing solutions for AMRs, but the pipeline coming forward as well"
To facilitate in building this capacity, while there is still “value and clinical use… on the therapeutic side for our existing classes of antibiotics and antifungals”, it is worth recognising the importance of “focusing on novel solutions, not just redeveloping old classes”.
However, she advocated the importance of “not only mitigating resistance but extending the use and the lifetime of our existing classes in parallel to working to develop novel classes”.
The future of AMR therapeutics
O'Neil underlined that from a commercial standpoint, “when antimicrobials work, [companies] do not make that much money from subscription models.”
Anticipating the future, she stated: “hopefully the benefits of subscription models kicking in on the more commercial side, we might see more activity on the R&D side from Pharma as well as then partnering with biotech, which they are doing to get drugs to patients.”
References
- Kraychete G, Bonelli R, Picão R. Green light for improving our understanding of AMR spread. The Lancet Microbe. 2023 Nov; 5(1). Available from: https://www.thelancet.com/journals/lanmic/article/PIIS2666-5247(23)00331-2/fulltext#back-bib1
- Comelli A, Zanforlini M, Mazzone A, et al. How a laboratory-based antimicrobial resistance (AMR) regional surveillance system can address large-scale and local AMR epidemiology: The MICRO-BIO experience. Public Health. 2024; 12; 12.


